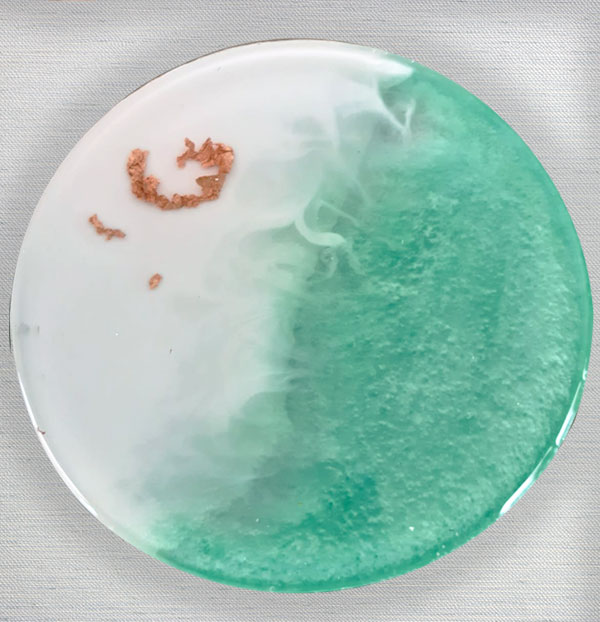

Totalmente Personalizados
Nosotros diseñamos con ustedes las piezas para que vayan de acuerdo a la decoración del evento.Tenemos opciones para todo tipo de presupuesto. Contacta a nuestros artesanos para crear la pieza ideal.
-
Pieza Resina
50-100 piezas $115 MXN/pieza
101-200 piezas $100 MXN/pieza
201 en adelante $90 MXN/pieza
-
Piezas Impresas en MDF y Resina
50-200 piezas $55 MXN/pieza
201 en adelante $50 MXN/pieza